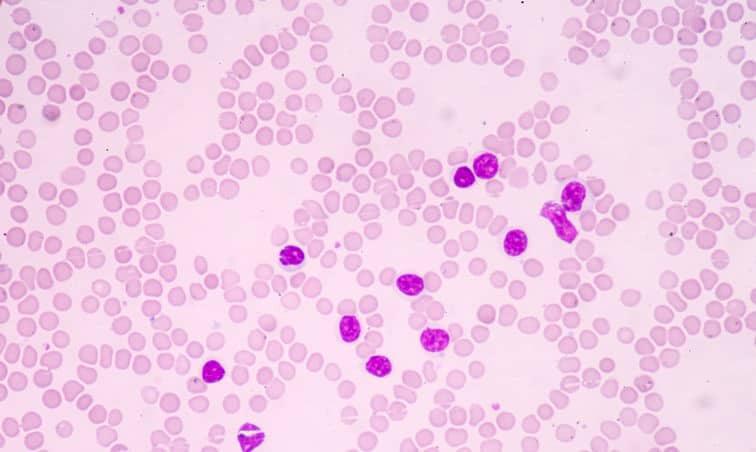
The Economic Burden Of Leukemia Treatment The Economic Burden Of Leukemia Treatment

-
The Economic Burden Of Leukemia Treatment
“The Economic Burden of Leukemia Treatment Related Articles The Economic Burden of Leukemia Treatment Sleep Disorders And Chronic Disease Relationships – Part…
-

Social Determinants Of Health And Chronic Disease Outcomes – Part 3
“Social Determinants of Health and Chronic Disease Outcomes – Part 3 Related Articles Social Determinants of Health and Chronic Disease Outcomes –…
-

Immunological Aspects Of Leukemia Therapy
“Immunological Aspects of Leukemia Therapy Related Articles Immunological Aspects of Leukemia Therapy Mental Health Interventions For Chronic Disease Patients – Part 9…
-

Bone Health In Indigenous Populations: Challenges And Solutions
“Bone Health in Indigenous Populations: Challenges and Solutions Related Articles Bone Health in Indigenous Populations: Challenges and Solutions Understanding Bone Fractures: Types,…
-

Dental Health And Bone Density: Interconnections
“Dental Health and Bone Density: Interconnections Related Articles Dental Health and Bone Density: Interconnections Advances In Bone Regeneration Techniques Common Types Of…
-

Bone Health And Healthcare Planning: A Comprehensive Guide
“Bone Health and Healthcare Planning: A Comprehensive Guide Related Articles Bone Health and Healthcare Planning: A Comprehensive Guide Bone Health And Access…
-

Innovations In Medical Devices For Chronic Disease Management – Part 5
“Innovations in Medical Devices for Chronic Disease Management – Part 5 Related Articles Innovations in Medical Devices for Chronic Disease Management –…
-

Social Support Networks For Chronic Disease Patients – Part 2
“Social Support Networks for Chronic Disease Patients – Part 2 Related Articles Social Support Networks for Chronic Disease Patients – Part 2…
-

The Role Of Exercise Oncology Programs In Leukemia Rehabilitation
“The Role of Exercise Oncology Programs in Leukemia Rehabilitation Related Articles The Role of Exercise Oncology Programs in Leukemia Rehabilitation Chronic Disease…
-

Sports Injuries And Bone Health: Prevention And Treatment
“Sports Injuries and Bone Health: Prevention and Treatment Related Articles Sports Injuries and Bone Health: Prevention and Treatment Absolutely! Here’s A Comprehensive…
-

Alternative Therapies In Leukemia Management: Evidence And Controversies
“Alternative Therapies in Leukemia Management: Evidence and Controversies Related Articles Alternative Therapies in Leukemia Management: Evidence and Controversies Financial Challenges Of Managing…
-

Alternative Therapies For Chronic Pain Management – Part 9
“Alternative Therapies for Chronic Pain Management – Part 9 Related Articles Alternative Therapies for Chronic Pain Management – Part 9 Emerging Therapies…